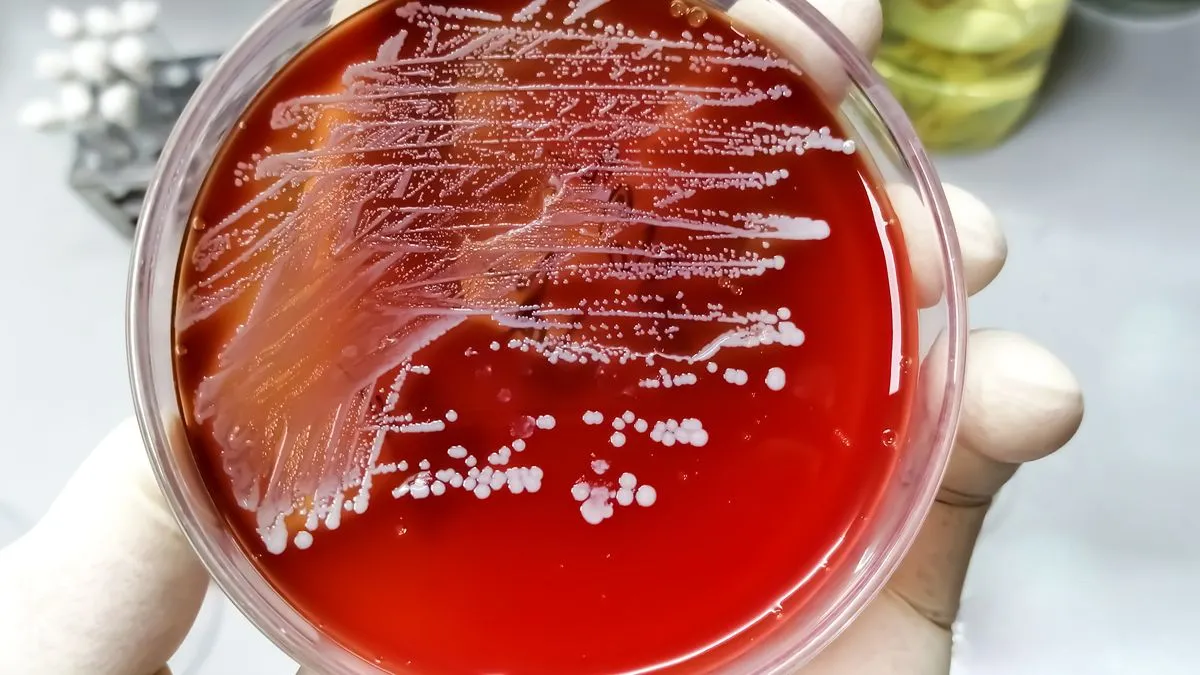
staphylococcus petrischaaltje

Aandacht voor antimicrobiële resistentie en antibioticabeleid blijft nodig
19 nov 2024, 13:05 • Nieuws
© Freep!k
Het percentage bacteriën in Nederland dat ongevoelig is voor antibiotica was in 2023 ongeveer gelijk aan voorgaande jaren. Dit blijkt uit onderzoek naar antibioticaresistentie.
Wel worden er steeds vaker zeer resistente bacteriën gevonden. Aandacht voor antimicrobiële resistentie en goed gebruik van antibiotica blijft daarom nodig.
Een bijzondere groep bacteriën zijn de zogenaamde ‘bijzonder resistente bacteriën’. Deze bacteriën zijn ongevoelig voor verschillende antibiotica. Zelfs voor antibiotica die alleen gebruikt worden wanneer andere antibiotica niet werken. Deze bijzonder resistente bacteriën komen regelmatig voor bij mensen die in het buitenland in het ziekenhuis hebben gelegen. Infecties door deze bacteriën zijn moeilijk te behandelen.
Antibioticagebruik bij mensen
Huisartsen hebben in 2023 ongeveer even vaak antibiotica voorgeschreven als in 2019, het jaar voor de coronapandemie. In de periode 2020-2022 gebeurde dat in Nederland minder vaak. In ziekenhuizen is in 2023 iets meer antibiotica gebruikt dan in de jaren voor de coronapandemie. Ook meldden ziekenhuizen en verpleeghuizen in 2023 meer uitbraken van infecties door resistente bacteriën dan in 2022. Dit was nog wel minder dan in de jaren voor de pandemie. Vergeleken met andere Europese landen is de antibioticaresistentie bij mensen in Nederland nog steeds relatief laag.
Maatregelen tegen antibioticaresistentie bij mensen
Maatregelen zoals handen wassen en andere hygiënemaatregelen, voorkomen infecties en zorgen ervoor dat resistente bacteriën zich minder verspreiden. Ook is het belangrijk dat antibiotica op de goede manier gebruikt worden en alleen als dat echt nodig is. Bacteriën worden namelijk resistent door onnodig en verkeerd gebruik van antibiotica.
Antibioticagebruik bij dieren
De maatregelen die Nederland neemt om antibioticaresistentie te bestrijden, reiken verder dan de maatregelen in de gezondheidszorg bij mensen. Resistente bacteriën komen namelijk ook voor bij dieren, in voeding en in het milieu. Door het naleven van strenge regels is het antibioticumgebruik in de Nederlandse veehouderij sinds 2009 flink gedaald. Die forse daling vlakt nu af. Ook de daling van antibioticaresistentie bij dieren zet niet verder door.
Sommige antibiotica zijn zeer belangrijk om infecties bij mensen te behandelen. Daarom krijgen landbouwhuisdieren deze alleen bij hoge uitzondering. Hierdoor komt resistentie tegen antibiotica die voor mensen belangrijk zijn, bij dieren relatief weinig voor.
Jaarlijks rapport NethMap(Consumption of antimicrobial agents and antimicrobial resistance among medically important bacteria in the Netherlands)/MARAN(Monitoring of antimicrobial resistance and antibiotic usage in animals in the Netherlands)
De resultaten over antibioticagebruik en -resistentie bij mensen en dieren staan in het rapport NethMap/MARAN 2024. Hierin presenteren verschillende organisaties samen de gegevens over het antibioticagebruik en -resistentie in Nederland.
Bron: RIVM
Loading articles...
Loading






